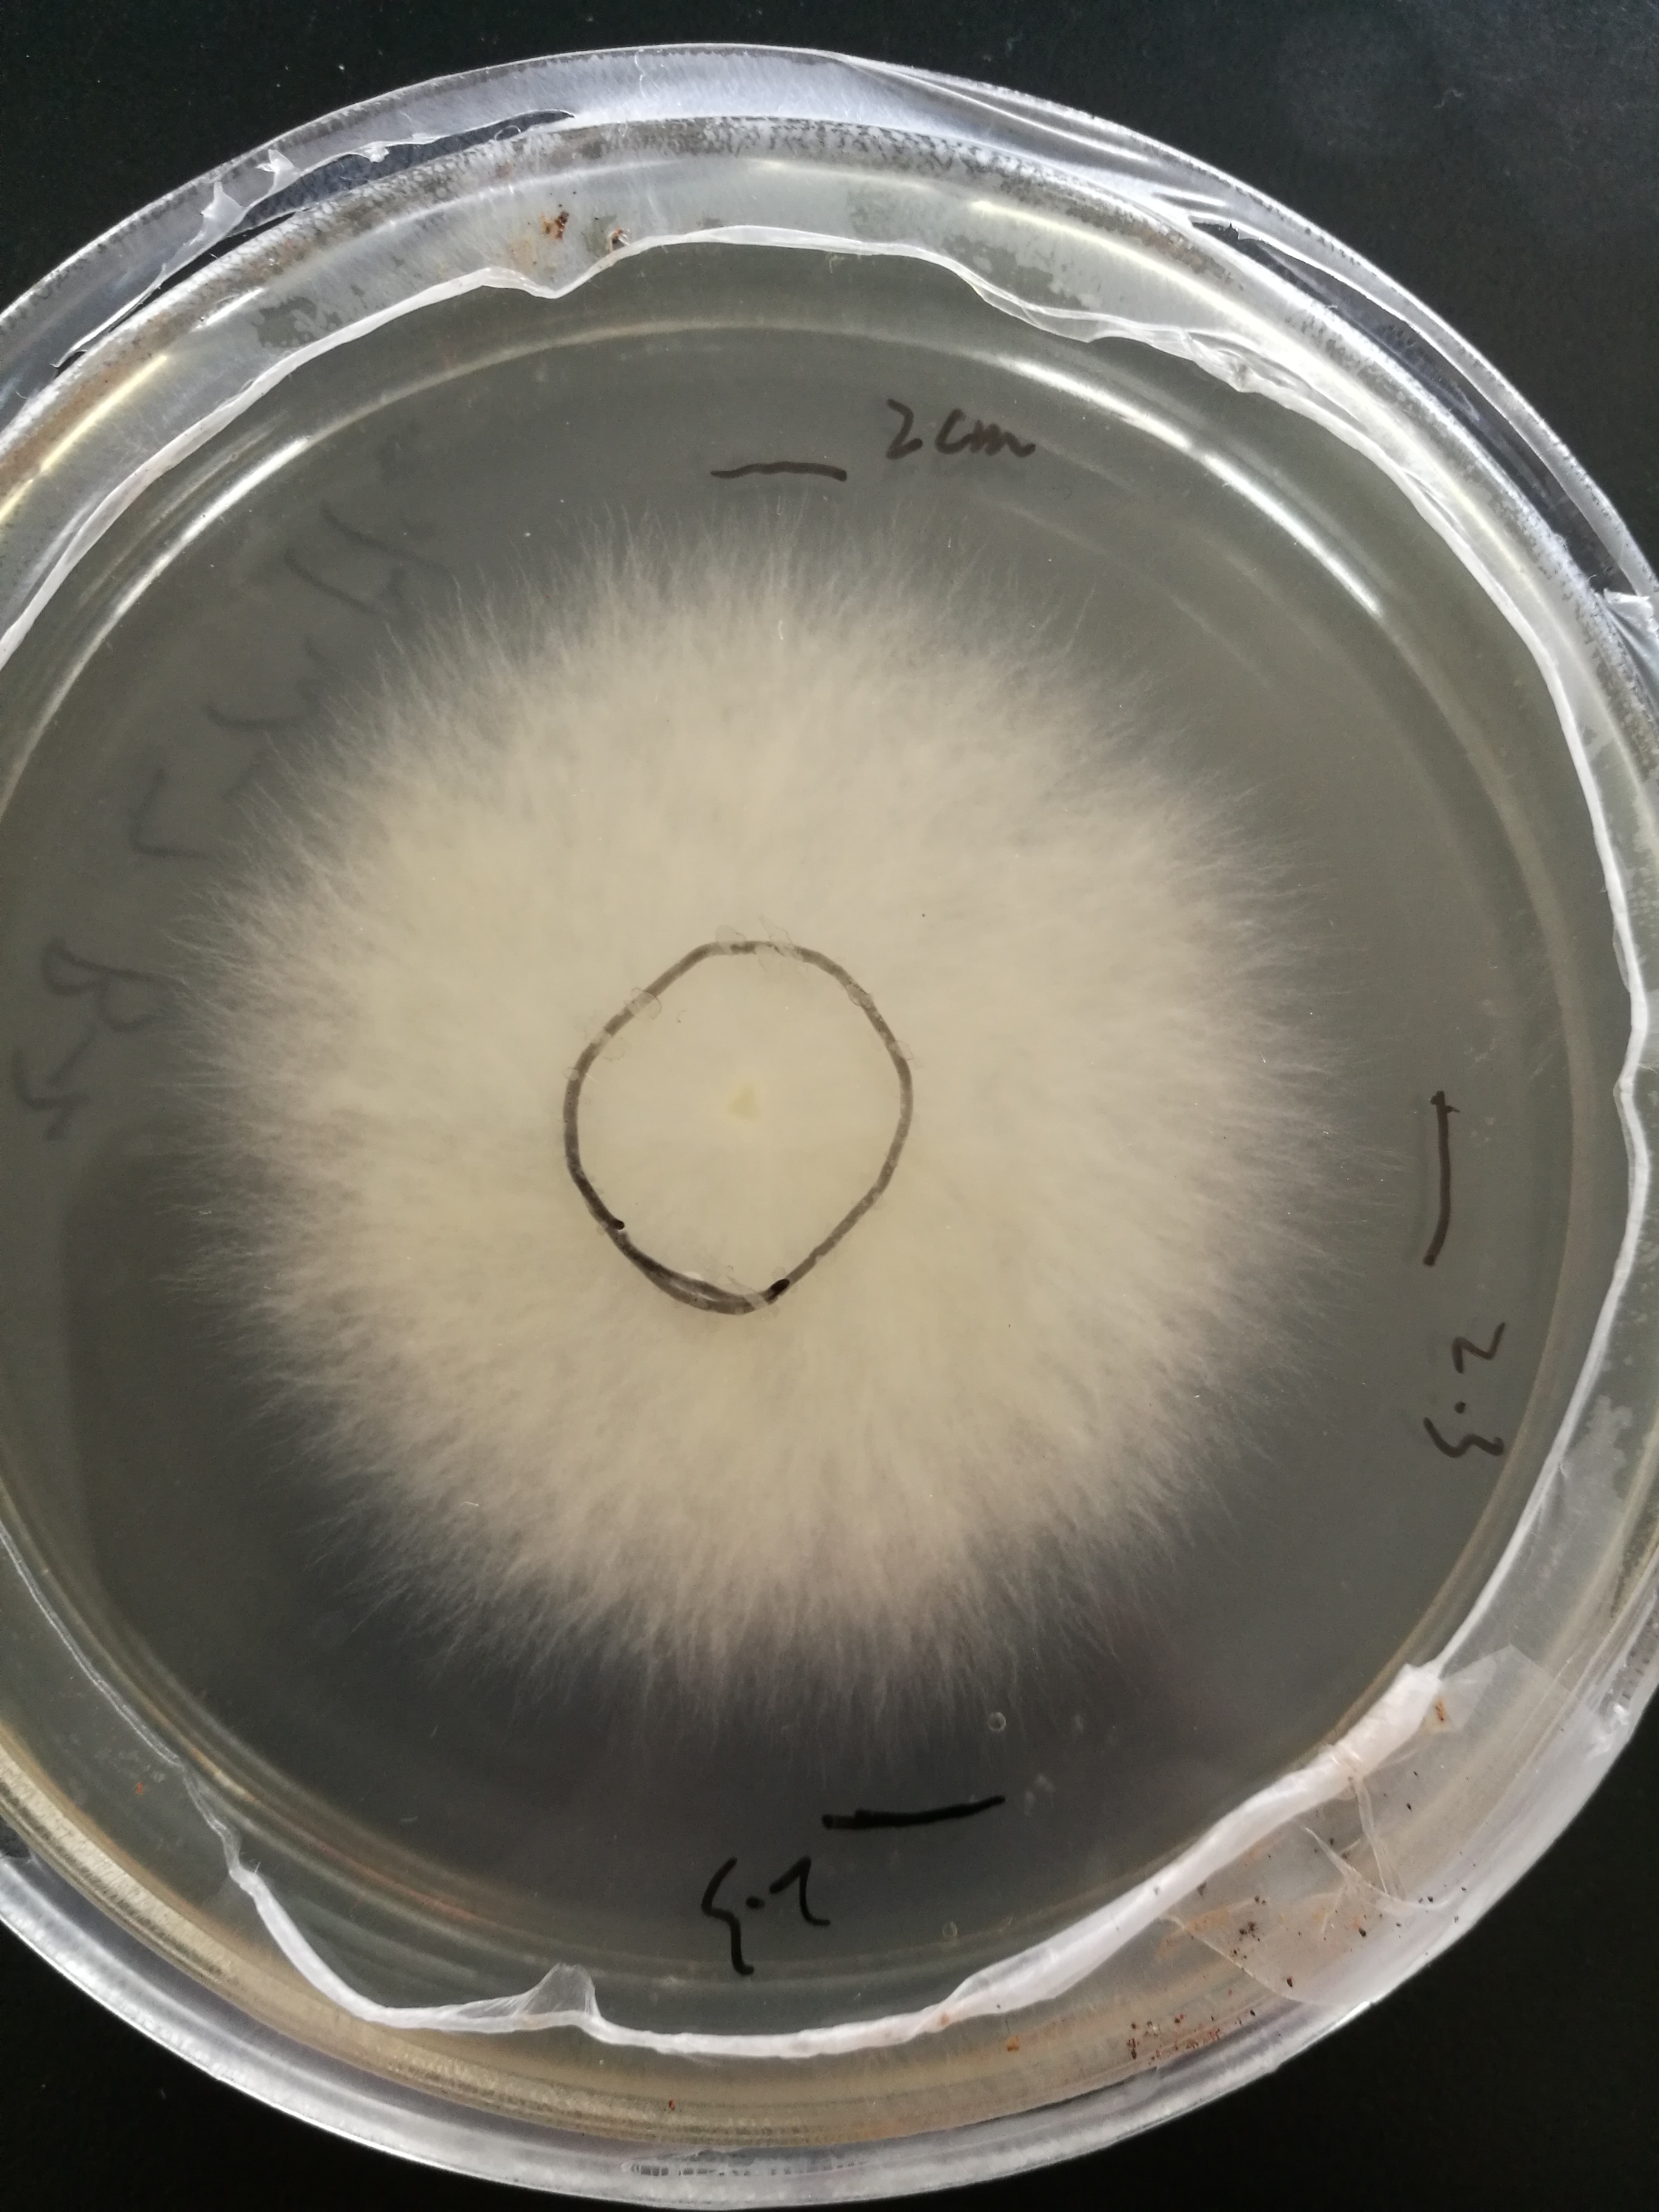
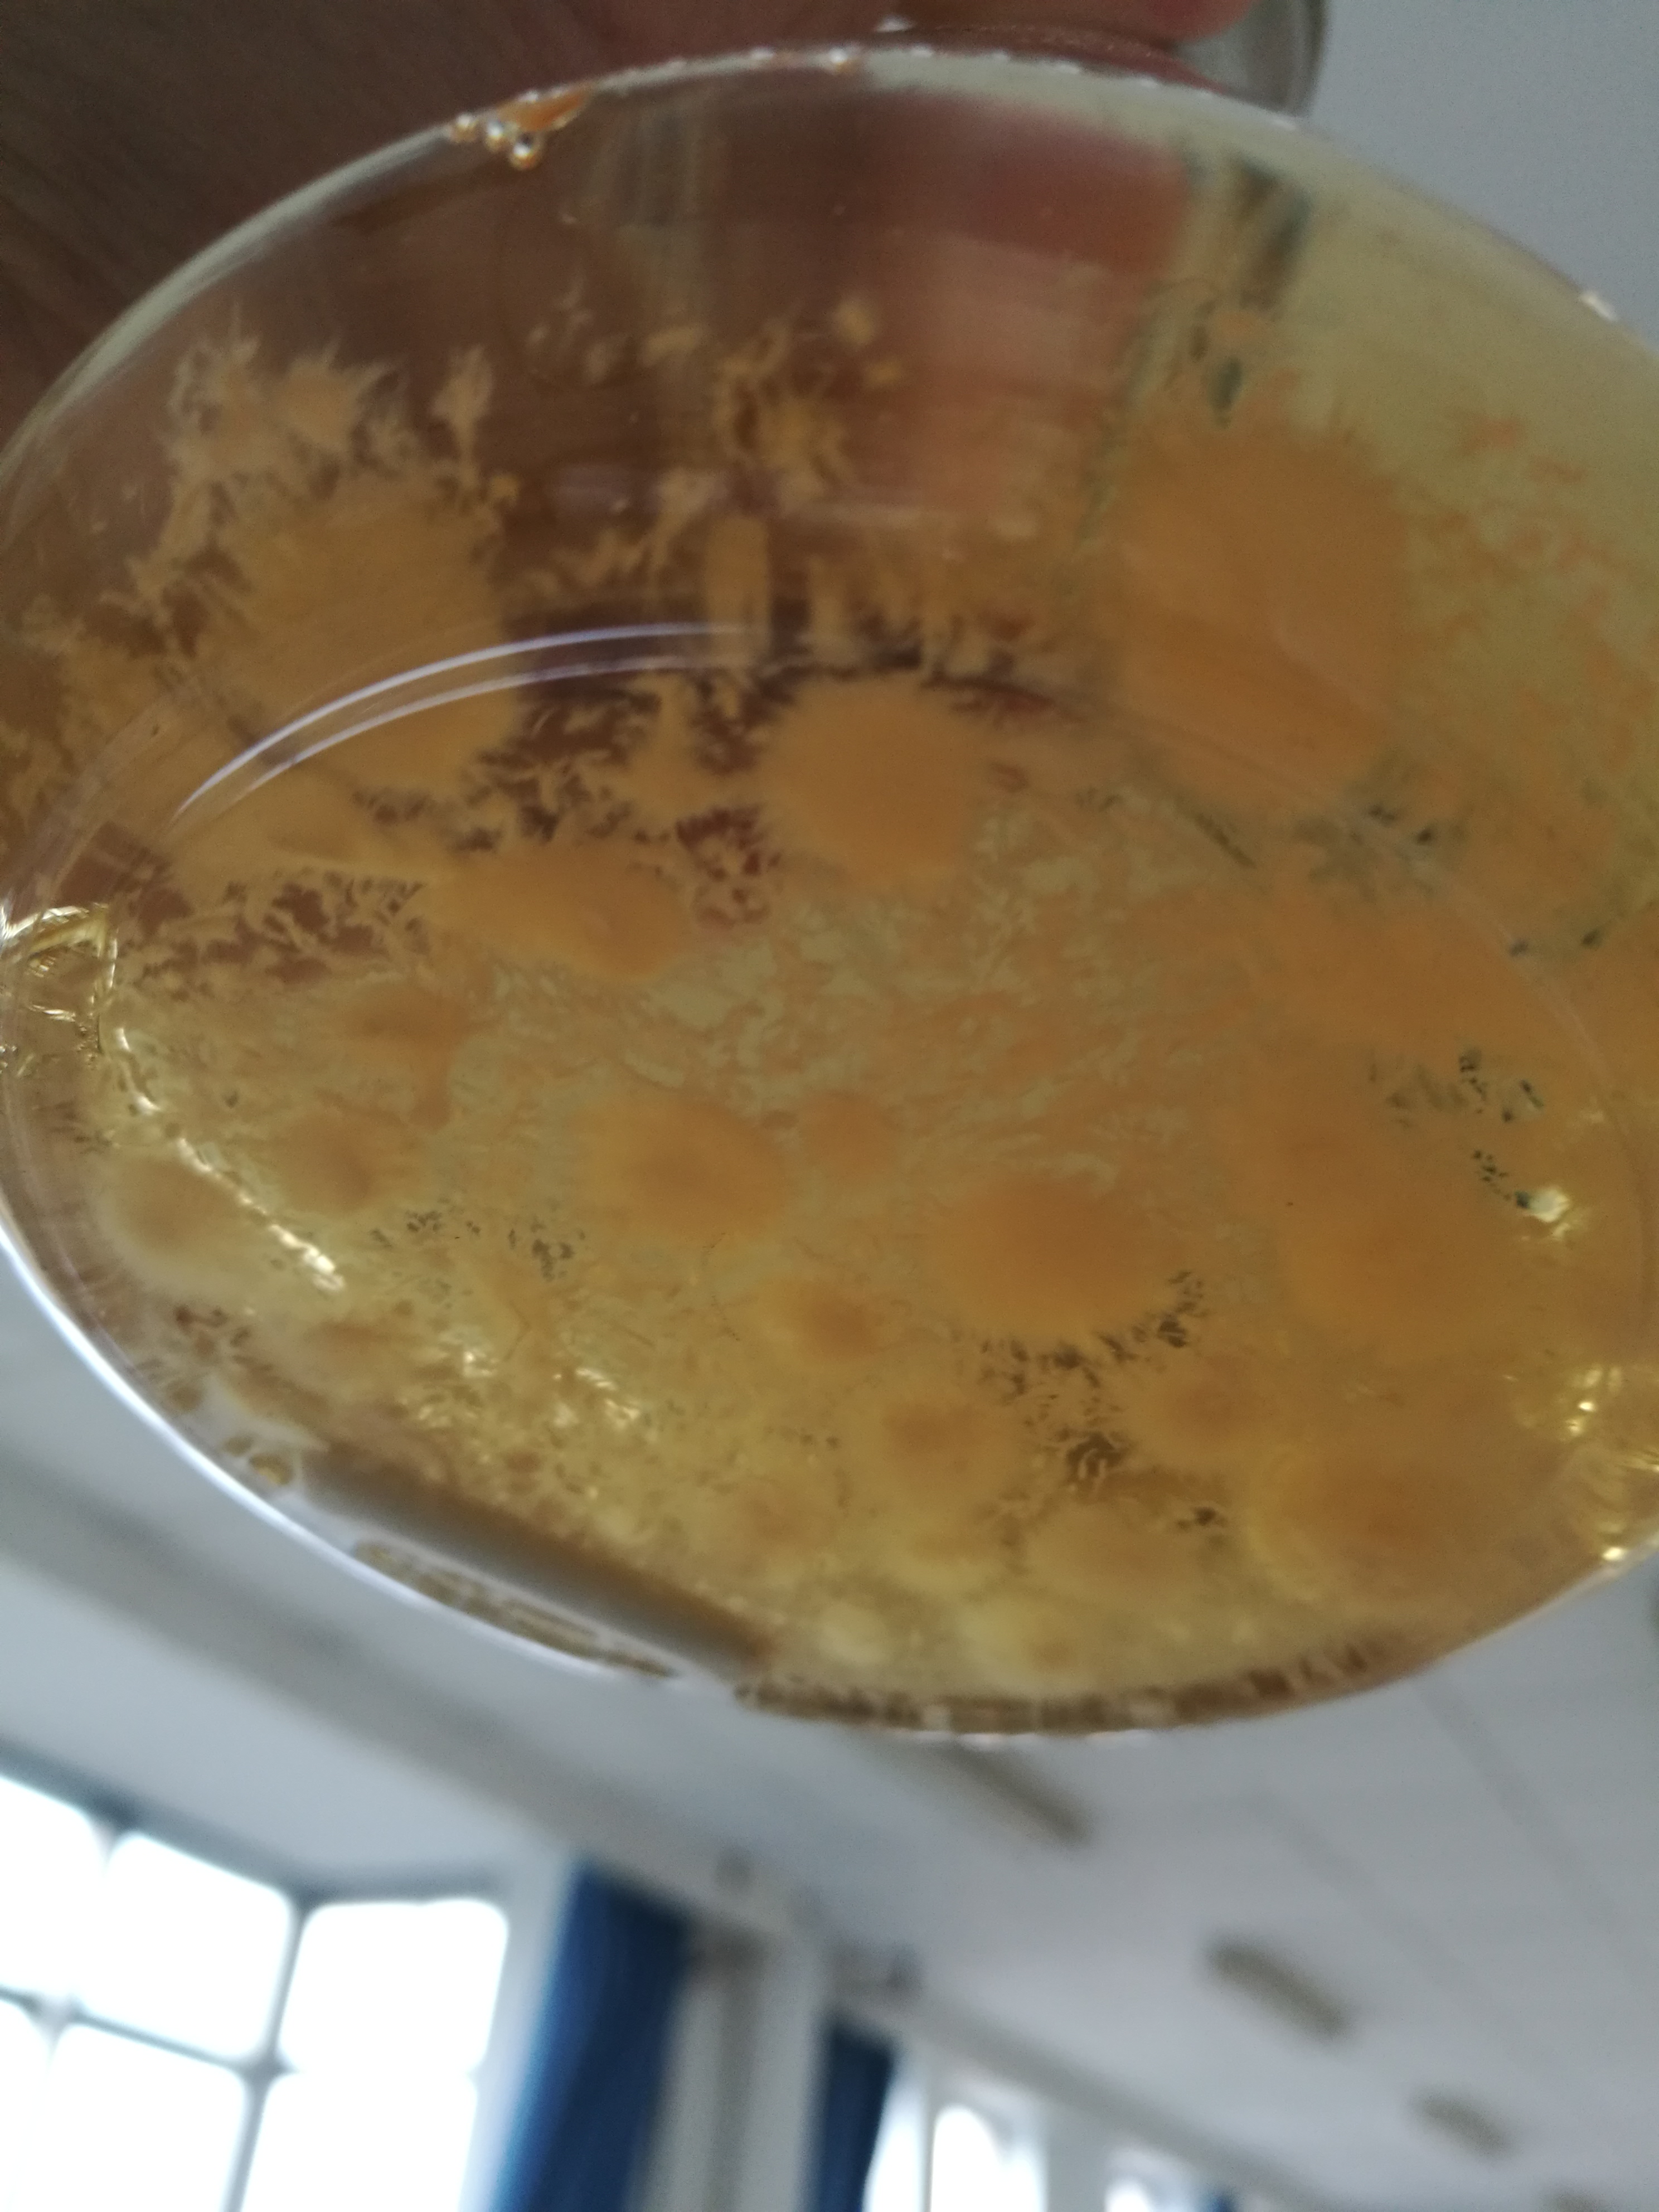

食用菌生产图片
上一节
下一节

培养皿中的食用菌种

斜面上的食用菌菌种

液体发酵的食用菌菌种

三角瓶中的食用菌菌种

扩大培养的食用菌菌瓶

等待出菇的食用菌栽培瓶

出菇中

成品鹿茸菇
目录
培养皿中的食用菌种

斜面上的食用菌菌种
液体发酵的食用菌菌种

三角瓶中的食用菌菌种

扩大培养的食用菌菌瓶

等待出菇的食用菌栽培瓶

出菇中

成品鹿茸菇